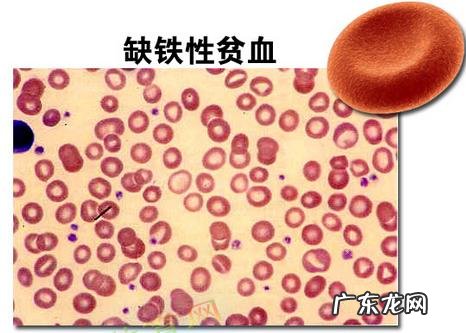
贫血吃什么,怎么补铁?

如果是缺铁引起的贫血 , 建议食用红肉、动物肝脏或动物血等补血食物 。
在食物中 , 铁的存在形式有两种 , 血红素铁和费血红素铁 。我们所说的补铁 , 补的是血红素铁 , 其主要存在于红肉、动物肝脏和动物血等动物性食物中 。
这些食物中的血红素铁含量丰富 , 平均在10~30毫克/100克 , 在在人体内吸收率也较高 , 为10%~40% 。
在食用上 , 建议成年人每天吃肉40~75克 , 每月食用动物肝脏2~3次 , 每次25克左右 , 经期的女性每月还可额外补充一份150~200克动物血 。
另外 , 红枣、菠菜等食物也可以补铁 , 但对比红肉、动物内脏等 , 优势并不大 。
比如红枣 , 其铁含量是2.3毫克/100克 , 与猪肝含铁量(22.6毫克/100克)相比 , 差远了 。而且 , 红枣中的铁主要是费血红素铁 , 这种铁的吸收率一般低于10% , 与上述红肉的10%~40%相比 , 也是很低的 。而菠菜的铁含量是猪肝的八分之一 , 也是非血红素铁 。
所以 , 如果贫血补铁 , 还是建议食用红肉、动物肝脏等 。21
贫血是指一定体积的血液内红细胞数量和血红蛋白含量低于正常范围内 , 一般分为缺铁性贫血、巨细胞贫血、再生障碍性贫血和溶血性贫血四大类[1] 。
缺铁性贫血是世界上最常见的营养性疾病 , 世界上超过30%的人患有贫血 , 而其中大多数是缺铁性贫血[2] 。
答案抢先知:
为了回答问题 , 本文只讲关于缺铁性贫血 。
超哥话食告诉你:一般动物性食物铁的含量和吸收率比较高 , 因此多吃动物肝脏、动物全血、畜禽肉类、鱼类等以此满足身体对铁的需要量[3] 。
文章插图
讲到缺铁性贫血吃什么 , 怎么补铁?我们首先要将缺铁性贫血发生的原因搞清楚 , 怎么通过调整膳食而有所改善 。
【缺铁性贫血发生的原因】
体内铁不足或缺乏 , 可导致缺铁性贫血 。
而铁缺乏的主要原因是膳食中铁摄入不足而机体对铁的摄入量增加 。另外 , 某些疾病如萎缩性胃炎、胃酸缺乏时 , 会影响铁离子释放 。女生月经过多 , 或肠道寄生虫等 , 也是引起铁缺乏的重要原因[3] 。

文章插图
【什么阶段的缺铁性贫血可以通过饮食补铁】
体内铁缺乏导致的缺铁性贫血可分为3个阶段 。
第一个阶段为铁储存减少期(ID) 。此时体内铁的储备逐渐减少 , 血清铁蛋白浓度降低 。如果仅仅为第一个阶段 , 我们可以先通过饮食补铁[2] 。
【吃什么 , 怎么补铁】
1、哪些食物含铁量高

文章插图
2、血红素铁的吸收率比非血红素高
食物中的铁分为血红素铁和非血红素铁 。血红素铁主要存在于动物性食品中 , 其吸收率比非血红素铁高 , 且吸收过程不受其他因素的干扰 。
如动物肉、肝脏中铁吸收率约为22% , 动物血为25% , 鱼类为11% 。非血红素铁主要存在于植物性食品中 , 吸收率较低 , 而且常受其他因素的干扰(如植物性食品中的草酸、植酸) 。大米、玉米、小麦铁的吸收率仅为1%~5%;黄豆稍高约为7%[3] 。
- 孕32周为什么会宫缩?有什么科学依据?
- 入冬瘦身两招让你再怎么吃也不胖
- 吃减肥药出现并发症怎么办
- 不吃主食减肥最终减掉的是健康
- 吃出苗条身材 白领“水果餐”最佳时间表
- 吃不胖的小Tips
- 什么原因让胖的人越吃越多?
- 白色门客厅配什么颜色墙面
- 饮杯美酒,兴到尽情,唱歌助兴,选一首什么歌曲好呢?
- 为什么会有祭祀用品?
特别声明:本站内容均来自网友提供或互联网,仅供参考,请勿用于商业和其他非法用途。如果侵犯了您的权益请与我们联系,我们将在24小时内删除。
